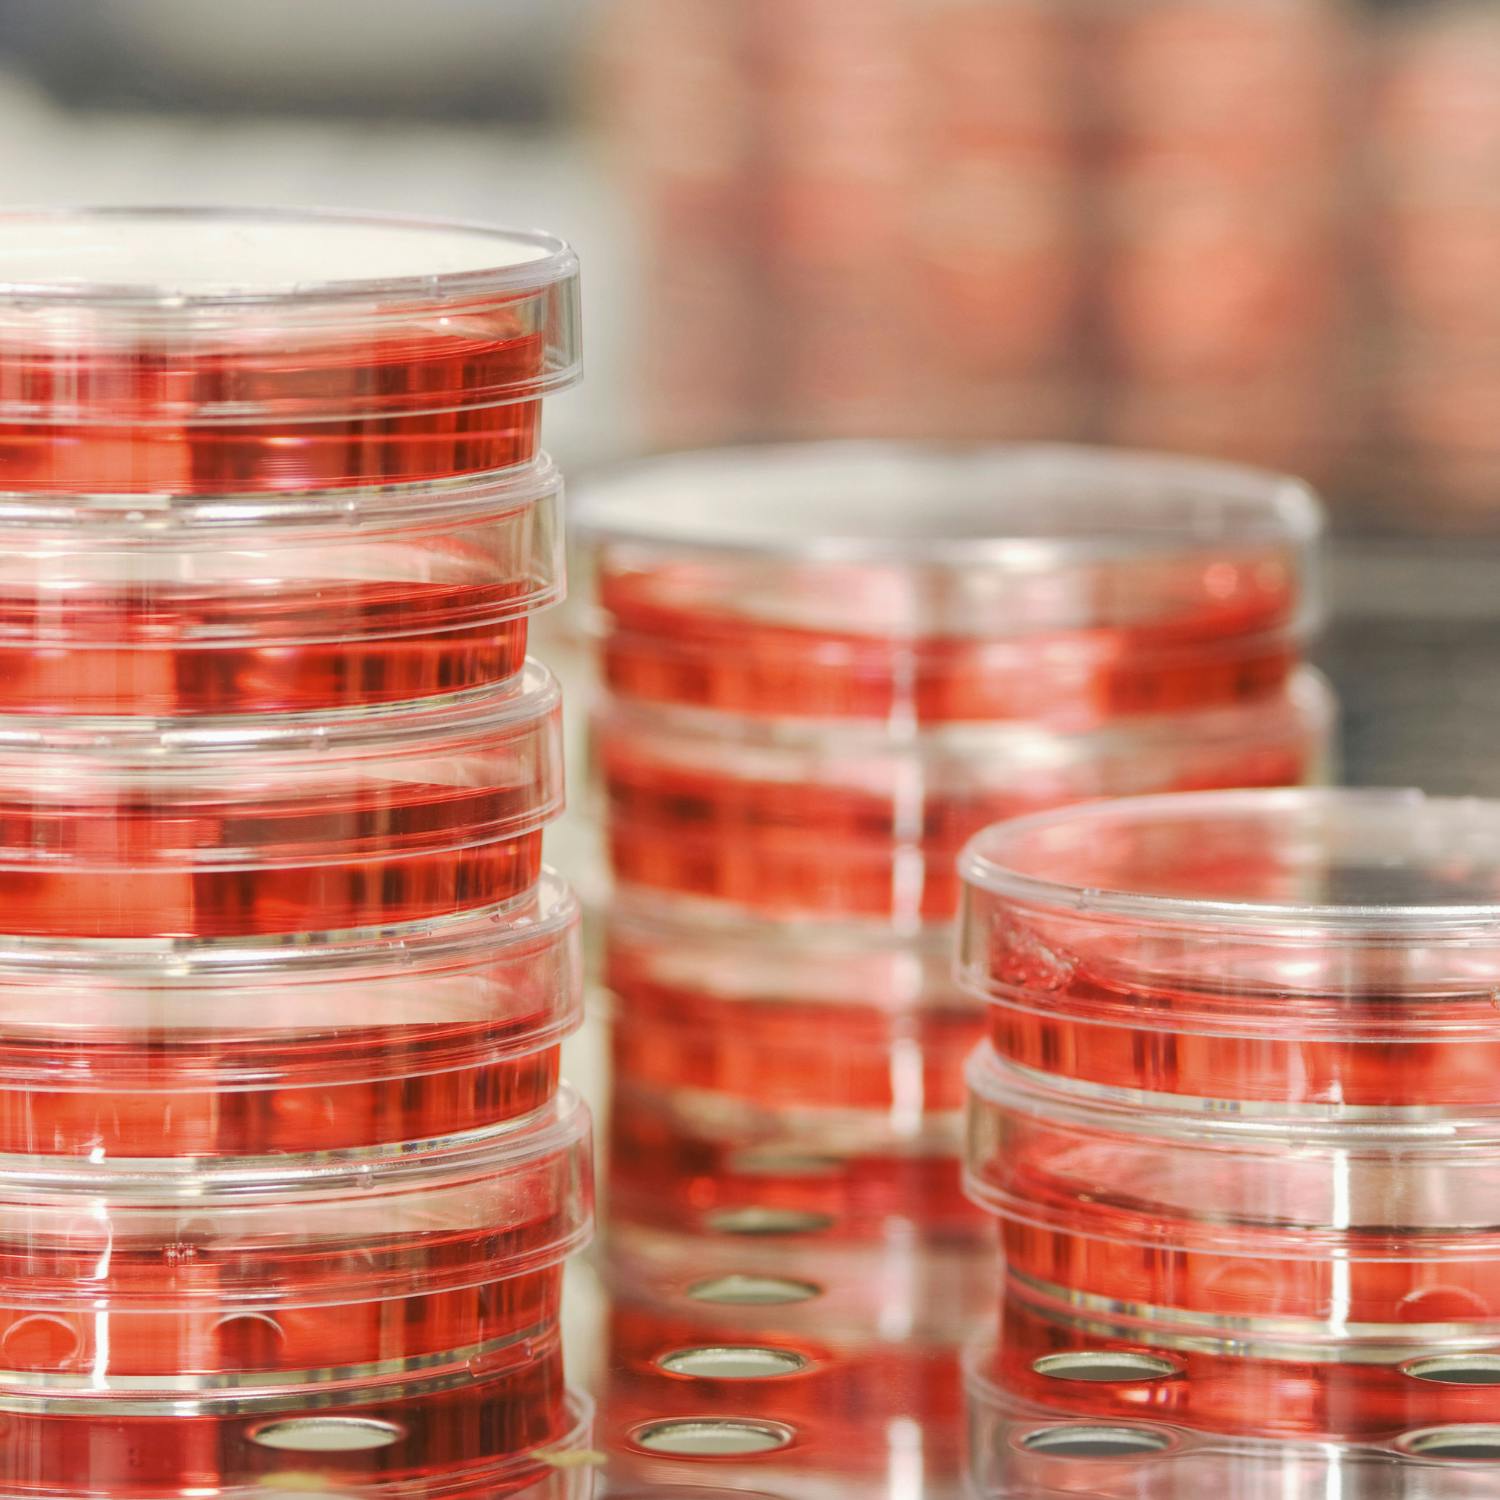

Ex HSE boss warns of spike in cancer due to Covid lockdowns
The Covid pandemic may be over, but cancer patients and their families will be counting the cost of Ireland\u2019s long lockdowns for years to come. That was the stark warning from former HSE boss Tony O\u2019Brien in the Business Post yesterday. \n\nSpeaking to Ciara with more on this was Professor Seamus O\u2019Reilly Consultant Medical Oncologist at Cork University Hospital.